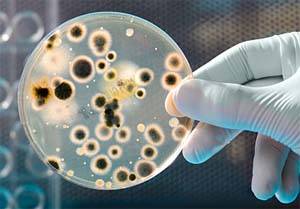

Вход в личный кабинет
Если Вы незарегистрированы на портале, то можете сделать это бесплатно. После регистрации Вы получите доступ в личный кабинет.
РегистрацияСтатьи компаний
Долбежные станки по металлу как инструмент точной геометрии деталей
ERP-система для металлообработки в 2026 году: зачем производству единая цифровая среда
Природный минерал Рутил с уникальными свойствами: области использования
Интуитивная сварка: Fabricator ET 400iP от ESAB — новая реальность Центральной Азии
«Стеллаж М»: производим и продаем металлические стеллажи, шкафы и верстаки без наценок
Безопасность при работах на действующих трубопроводах: оборудование и технологии
Биоцидные присадки в СОЖ предотвращающие гниение и закисание
« к списку статей
05.11.2014 СОЖ для металлообработки
Идеальных СОЖ в природе не существует. Все зависит от уровня культуры производства, загрязненности технологического процесса.
В случае необходимости корректировать эмульсию при появлении признаков биопоражения можно отдельно добавляемыми присадками-биоцидами: \"АМП\", \"Базин\", \"Acticide MV-14\" (Thor) и др.
Периоды коррекции каждое предприятие устанавливает самостоятельно, в зависимости от своего технологического процесса, от быстроты загрязнения эмульсии. Коррекция производится не просто так, а после периодической проверки эмульсии СОЖ на биопоражение, и если поражение составляет от 2-х баллов и выше.
Проверки производят работники аттестованной заводской лаборатории. Используются био-тесты (\"Дипслайды\"), это такие тест-пробирки.
Если на заводе нет лаборатории, применить их может технолог или механик - тот специалист, который контролирует эксплуатацию эмульсии СОЖ.
Мы рекомендуем использовать \"Acticide MV-14\" (Thor).
Статья опубликована от компании: СОЖ для металлообработки
Ещё анонсы и статьи
09.06.2026 SteelSite.ru
Долбежные станки по металлу как инструмент точной геометрии деталейВ металлообработке есть задачи, которые невозможно решить универсальным оборудованием. Когда требуется формирование внутренних пазов, шлицев или сложных профилей, на первый план выходят долбежные стан...
Читать далее »09.06.2026 SteelSite.ru
ERP-система для металлообработки в 2026 году: зачем производству единая цифровая средаМеталлообработка относится к тем видам производства, где ошибка в планировании, учете материалов или расчете сроков быстро отражается на себестоимости и загрузке цеха. В одном заказе могут быть задейс...
Читать далее »28.05.2026 SteelSite.ru
Природный минерал Рутил с уникальными свойствами: области использованияПриродный материал, известный своей уникальной способностью преломлять световые лучи, занимает важное место в различных отраслях хозяйственной деятельности. Этот компонент отличается характерным внешн...
Читать далее »28.05.2026 ESAB
Интуитивная сварка: Fabricator ET 400iP от ESAB — новая реальность Центральной АзииВ промышленной сварке ключевыми вызовами остаются стабильность дуги, бесперебойность процесса сварки и минимизация влияния человеческого фактора. Любые отклонения в процессе могут привести к браку, пр...
Читать далее »08.05.2026 SteelSite.ru
«Стеллаж М»: производим и продаем металлические стеллажи, шкафы и верстаки без наценокМеталлический стеллаж с полками при правильном выборе служит десятилетиями и не требует замены. «Стеллаж М» с 2008 года производит металлические стеллажи, шкафы и верстаки - для склада, шиномонтажа, а...
Читать далее »Copyright © 2009-2026 SteelSite.ru - Металлургический портал, оборудование для обработки металлов, металлургическая продукция.

